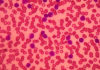
Хронический лимфоцитарный лейкоз (ХЛЛ)

Аденокарцинома поджелудочной железы
Вторичные злокачественные опухоли шеи
Гепатома (гепатоцеллюлярная карцинома)
Злокачественная лимфома кости (ретикулярноклеточная саркома)
Злокачественные опухоли головы и шеи
Злокачественные опухоли легкого
Злокачественные опухоли миндалины
Злокачественные опухоли носоглотки